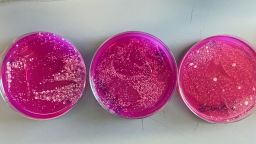
Вспышка сальмонеллёза в нескольких штатах может быть связана с устрицами. Что следует знать людям.

Отзывы о рекламе Здоровье и благополучие 6 мин чтения Вспышка сальмонеллеза в нескольких штатах может быть связана с устрицами. Что следует знать людям Автор

Катя Хеттер. Обновлено 31 декабря 2025 г., 11:01 по восточному времени. Опубликовано 31 декабря 2025 г., 11:01 по восточному времени. Размещено 31 декабря 2025 г., 11:01 по восточному времени.

Устрицы часто едят в сыром виде или слегка приготовленными, а это значит, что термическая обработка для уничтожения бактерий не требуется. Ant DM/iStockphoto/Getty Images Еда и здоровье Смотрите все темы Facebook Твитнуть Email Ссылка Ссылка скопирована! Подписаться
Согласно сообщению Центров по контролю и профилактике заболеваний США, вспышка сальмонеллезных инфекций, предположительно связанная с употреблением сырых устриц, затронула более 60 человек в 22 штатах.
В предупреждении, опубликованном 23 декабря, говорится, что представители органов здравоохранения работают над установлением источника заражения сырыми устрицами.
Что такое сальмонелла и как она вызывает заболевания? Как устрицы заражаются, и безопасно ли их есть? Что следует знать, если устрицы будут в меню на предстоящих общественных мероприятиях? Какие группы населения наиболее уязвимы к тяжелым заболеваниям? Какие другие виды морепродуктов могут представлять подобный риск, и как можно снизить вероятность заболевания?
Чтобы получить ответы на эти вопросы, я обратилась к эксперту CNN по вопросам здоровья и благополучия, доктору Леане Вэнь. Вэнь — врач скорой помощи и клинический доцент Университета Джорджа Вашингтона. Ранее она занимала должность комиссара здравоохранения Балтимора, в обязанности которой входил надзор за безопасностью пищевых продуктов.
CNN: Что такое сальмонелла и как она вызывает заболевание?
Доктор Леана Вэнь: Сальмонелла — это группа бактерий, вызывающих одну из самых распространенных пищевых инфекций в Соединенных Штатах. Люди обычно заражаются после употребления в пищу продуктов, загрязненных этими бактериями. Попав в организм, сальмонелла вызывает воспаление, которое приводит к желудочно-кишечному заболеванию.
Сальмонелла часто встречается в недостаточно термически обработанной птице, яйцах и зараженных продуктах, но также может содержаться в морепродуктах, включая устрицы. Поскольку бактерии невидимы и не меняют запах или вкус пищи, люди обычно не получают никаких предупреждений о том, что употребляемая ими пища может вызвать у них заболевание.
Статья по теме

CNN: Какие симптомы испытывают люди, и как лечится это заболевание?
Вэнь: Симптомы сальмонеллезной инфекции обычно проявляются в течение шести часов — нескольких дней после заражения. К распространенным симптомам относятся диарея, спазмы в животе, лихорадка, тошнота и рвота. Многие также чувствуют усталость и обезвоживание. У большинства здоровых взрослых симптомы длятся от четырех до семи дней и проходят сами по себе без специального лечения.
Лечение носит преимущественно поддерживающий характер. Наиболее важным шагом является поддержание водного баланса, особенно при частой диарее. Растворы для пероральной регидратации помогают восполнить потерянную жидкость и электролиты. Безрецептурные жаропонижающие средства, такие как парацетамол или ибупрофен, могут помочь справиться с дискомфортом, если их использовать правильно и не превышать рекомендуемые дозы. Антибиотики не рекомендуются, за исключением случаев тяжелого заболевания или высокого риска осложнений, поскольку они могут продлить период носительства бактерий.
Статья по теме

CNN: Кто наиболее уязвим к тяжелому течению сальмонеллезной инфекции?
Вэнь: Хотя большинство людей быстро выздоравливают после заражения сальмонеллой, некоторые группы населения подвержены гораздо более высокому риску тяжелого течения заболевания. К ним относятся взрослые старше 65 лет, младенцы и маленькие дети, беременные женщины, а также все, у кого ослаблен иммунитет из-за таких заболеваний, как рак, диабет, заболевания почек или приема лекарств, подавляющих иммунитет.
У людей из группы риска сальмонелла с большей вероятностью распространяется за пределы кишечника в кровоток, вызывая серьезные инфекции, требующие госпитализации и лечения антибиотиками. Беременность также может повысить риск осложнений для плода. Из-за этих рисков людям из групп высокого риска следует полностью избегать употребления сырых устриц.
Видео по теме
видео
CNN: Как устрицы загрязняются, и безопасно ли их есть?
Вэнь: Устрицы — фильтраторы, то есть они всасывают большие объемы воды для извлечения питательных веществ. Если вода, в которой их добывают, загрязнена бактериями из сточных вод, эти патогены могут накапливаться внутри устрицы. В отличие от некоторых других продуктов, устрицы часто едят сырыми или слегка приготовленными, а это значит, что нет этапа нагревания для уничтожения бактерий.
Тщательная термическая обработка устриц значительно снижает риск заражения, поскольку высокая температура убивает сальмонеллу и другие патогенные микроорганизмы. Употребление сырых устриц всегда сопряжено с определенным риском, даже если они выловлены в разрешенных водах и обрабатываются в соответствии с правилами. Тестирование и мониторинг снижают риск, но не могут полностью его исключить. Именно поэтому представители органов здравоохранения постоянно предупреждают, что сырые или недостаточно термически обработанные устрицы никогда не бывают полностью безопасны для употребления.
CNN: Что следует знать, если устрицы включены в меню для общественных мероприятий?
Вэнь: Если подают устрицы, важно знать, сырые они или полностью приготовленные. Приготовленные устрицы должны быть очень горячими и приготовлены таким образом, чтобы достичь безопасной внутренней температуры. Устрицы в раковинах следует готовить на пару от четырех до девяти минут в пароварке, которая уже нагрета. Очищенные от раковин устрицы следует варить, запекать или жарить не менее трех минут.
Если вы принимаете гостей, подумайте о том, чтобы предложить им приготовленные морепродукты вместо сырых устриц или четко обозначьте, какие блюда сырые, а какие недоваренные, чтобы гости могли сделать осознанный выбор. Избегайте перекрестного загрязнения, храня сырые морепродукты отдельно от приготовленных блюд и используя разные столовые приборы.
Кроме того, если устрицы подаются в сыром виде, их следует хранить в холодильнике до подачи. Выбросьте их, если они находились на открытом воздухе более двух часов, или одного часа, если в помещении очень жарко.
Статья по теме

Руки горничной моют помидоры, свежие овощи, готовят здоровую пищу на кухне.
CNN: Убивает ли сальмонеллу острый соус, сок лайма или лимона?
Вэнь: Нет. Единственный способ гарантированно уничтожить сальмонеллу и другие патогены — это готовить блюдо до тех пор, пока внутренняя температура не достигнет как минимум 145 градусов по Фаренгейту (около 63 градусов по Цельсию) в течение как минимум 15 секунд.
CNN: Какие еще виды морепродуктов могут представлять подобную опасность?
Вэнь: Сырые или недостаточно приготовленные морепродукты могут содержать множество бактерий и вирусов, а не только сальмонеллу. Сырые моллюски, такие как мидии, гребешки и другие, могут содержать патогены, попавшие в организм из загрязненной воды. Некоторые виды рыбы могут быть переносчиками паразитов, если их употреблять в сыром или недостаточно приготовленном виде. Кроме того, морепродукты могут представлять опасность, если их неправильно обрабатывать или хранить.
Помимо морепродуктов, аналогичные принципы безопасности пищевых продуктов применимы и к другим продуктам с высоким риском заражения. Непастеризованные молочные продукты, недостаточно приготовленное мясо и птица, а также сырые яйца являются распространенными источниками пищевых отравлений. Ключевой момент во всех этих продуктах заключается в том, что патогенные микроорганизмы с большей вероятностью выживают, если употреблять пищу в сыром виде или неправильно приготовленной.
Статья по теме

Лонг-Бич, Калифорния — 1 октября: Шелли Мур, исполнительный директор Института исследований загрязнения пластиком имени Мура, использует стереоскоп для изучения образца осадка с целью выявления микропластика, его сортировки, анализа на тип полимера, измерения и определения вида частиц. Фотография сделана в Лонг-Бич во вторник, 1 октября 2024 года. (Фото Леонарда Ортиса/MediaNews Group/Orange County Register через Getty Images)
CNN: Как можно снизить вероятность заражения сальмонеллой?
Вэнь: Самый эффективный способ снизить риск — избегать употребления сырых или недоваренных морепродуктов, включая устрицы. Правильная обработка продуктов также имеет значение. Мойте руки с мылом и водой до и после работы с сырыми морепродуктами. Чистите и дезинфицируйте разделочные доски, ножи и поверхности, контактирующие с сырыми продуктами. Храните сырые морепродукты и мясо отдельно от приготовленных и готовых к употреблению продуктов, чтобы предотвратить перекрестное загрязнение. Незамедлительно убирайте продукты в холодильник и никогда не оставляйте скоропортящиеся продукты на длительное время.
Статья по теме

Тем, кто, несмотря на риски, употребляет в пищу сырые устрицы, особенно важно обращать внимание на рекомендации органов здравоохранения и информацию об отзыве продукции. При появлении таких симптомов, как кровавая диарея, высокая температура или сильная рвота, из-за которой вы не можете удерживать жидкость в желудке, обратитесь за медицинской помощью, особенно если вы относитесь к группе повышенного риска.
Мой вывод таков: морепродукты могут быть частью здорового питания, но их нужно готовить и употреблять безопасно. Во время таких вспышек заболеваний, как эта, необходима особая осторожность. Принятие осознанного решения сейчас поможет сохранить приятные воспоминания о праздниках, а не избежать неожиданной болезни.
Вдохновляйтесь еженедельной подборкой простых и эффективных способов жить хорошо. Подпишитесь на рассылку CNN «Жизнь, но лучше», чтобы получать информацию и инструменты, разработанные для улучшения вашего самочувствия.
Еда и здоровье Посмотреть все темы Facebook Твитнуть Email Ссылка Ссылка скопирована! Подписаться












